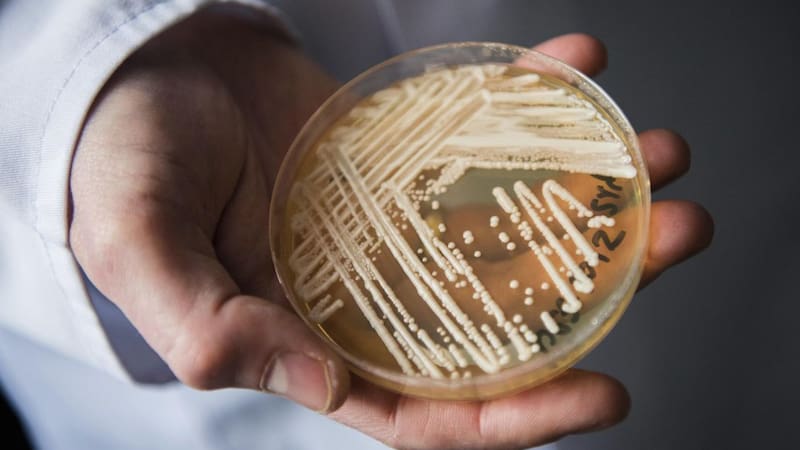

Por María José GómezEste hongo letal resistente a tratamientos se propaga rápidamente en Estados Unidos
Según una investigación publicada en la revista American Journal of Infection Control, desde 2019 se ha registrado un alarmante crecimiento de los casos de infecciones por Candida auris.
Un hongo mortal, descrito anteriormente como una “amenaza urgente” por los Centros para el Control y la Prevención de Enfermedades (CDC, por sus siglas en inglés), ha experimentado una drástica alza en su propagación según un nuevo estudio.
Se trata de Candida auris o C. auris, que se caracteriza por provocar infecciones graves y por ser resistente a los medicamentos antimicóticos. Esto causa que los gérmenes no mueran con el tratamiento y continúen creciendo.
Si bien no suele afectar a la población sana, puede proliferar rápidamente en los recintos de atención médica, donde las personas están con un estado de salud más vulnerable. Afecta en su mayoría a pacientes con enfermedades graves y que deben estar conectados a dispositivos médicos, como sondas de alimentación, sondas respiratorias y catéteres urinarios.
Según una investigación publicada el pasado 17 de marzo en la revista American Journal of Infection Control, los casos de C. auris han subido “rápidamente” en Estados Unidos.

Qué se sabe del aumento de infecciones por Candida auris en Estados Unidos
El reciente informe de investigadores estadounidenses se centró en el Sistema de Salud Jackson de Miami, Florida.
Luego de analizar los casos registrados entre el 1 de abril de 2019 y el 31 de diciembre de 2023, el equipo determinó que “los volúmenes de cultivos clínicos con C. auris han aumentado rápidamente, acompañado de una expansión de las fuentes de infección”.
En 2019 se registraron 5 casos de infecciones, y desde entonces, las cifras solo han crecido: 29 en 2020, 71 en 2021, 107 en 2022 y 115 en 2023. Los investigadores describen en su estudio que “los hemocultivos fueron la fuente más común, pero las muestras procedentes de infecciones de tejidos blandos/huesos experimentaron un gran aumento en 2022 y 2023”.
La investigación fue publicada un par de días después de que JoAnna Wagner, del Departamento de Salud Pública de Georgia, indicara al medio local WJCL que los casos también han proliferado significativamente en ese estado.

Hasta fines de febrero, se registraron 1.300 casos en Georgia, según Wagner. “Muchos de los desinfectantes registrados por la EPA y utilizados históricamente por hospitales e instalaciones médicas no son eficaces contra C. auris”, comentó la especialista.
Timothy Connelly, doctor de Memorial Health en Savannah, dijo al mismo medio que han tenido cuatro pacientes infectados a la vez, “de forma intermitente”, en los últimos meses.
En 2023, los especialistas de los CDC calificaron a C. auris como una “amenaza urgente de resistencia a los antimicrobianos (RA)”, luego de haber notado en un estudio que se propagó a un ritmo acelerado en los centros sanitarios de Estados Unidos entre 2020 y 2021.
“El rápido aumento y la propagación geográfica de los casos es preocupante y pone de relieve la necesidad de una vigilancia continua, una mayor capacidad de laboratorio, pruebas de diagnóstico más rápidas y la adhesión a las medidas de prevención y control de infecciones comprobadas”, dijo en ese entonces la Dra. Meghan Lyman, epidemióloga de los CDC y autora de la investigación.
Según datos de la agencia de salud, entre 2016 y 2023 se han detectado alrededor de 10.778 casos en el país, donde los estados más afectados han sido Nueva York, Illinois, California y Florida.
COMENTARIOS
Para comentar este artículo debes ser suscriptor.
Lo Último
Lo más leído
2.
4.


















